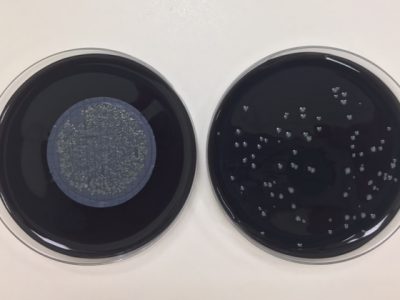

Sale a consulta pública la norma PNE 100030 sobre Legionella
Desde Ambientalys os informamos de que ha salido a consulta pública la norma PNE 100030 sobre #Legionella que marcará las nuevas directrices de la normativa... Read More
Ambientalys celebra 10 años como laboratorio en Valencia
Una década de dedicación, motivación y esfuerzo. Así resumimos los 10 años de Ambientalys, 10 años operando como laboratorio en Valencia pero ofreciendo un servicio... Read More
Qué posibilidades tenemos a la hora de analizar la legionella
Últimamente nos estamos encontrando consultas de clientes que nos indican que les damos valores de legionella <100 ufc/l y nos pregunta que cómo es posible... Read More
Cursos de Legionela: Inscripción ya disponible
En Ambientalys contamos con un equipo altamente cualificado y especializado en el tratamiento de aguas que se encarga de impartir cursos de Legionela para técnicos... Read More
Abierto plazo de inscripción: Curso de Especialización CAI en Contaminación Atmosférica
AVEMCAI junto a la colaboración de Ambientalys, abre el plazo de inscripción al primer Curso de Especialización CAI en Contaminación Atmosférica
Analiza el agua de tu piscina para la temporada de verano
Escrito por Juan Jesús López, Asesor técnico en Ambientalys. Con el buen tiempo llega la temporada de baño y, por tanto la apertura de multitud... Read More
Abierto plazo de inscripción: Curso inicial de Legionella
Ya está disponible un nuevo curso inicial de Legionella impartido por el equipo de profesionales de los Laboratorios Ambientalys. Entre los días 13, 15, 20, 22, 23... Read More
Laboratorio de alimentos: Sobre el etiquetado de los alimentos
Escrito por Enedina Hurtado López, Responsable de Microbiología en Ambientalys Consultoría y Análisis. Hace 5 años que se publicó el Reglamento (UE) 1169/2011 sobre la... Read More
Higiene ambiental: Que los hongos no destruyan la historia
Hace un tiempo realizamos un trabajo muy interesante en un depósito archivístico sobre la contaminación fúngica en carpetas donde se archivaban documentos históricos (documentos con... Read More
Queremos razones, no “parches”
Escrito por Fernando Francisco Galván, Director Comercial en Ambientalys Consultoría y Análisis. El otro día me encontraba liado con el cierre del año y las... Read More